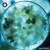
Penicillium Calcium sugar spheres in precise orb format for energetic homeopathic (nonmedical) dry-form formulation and storage

Origin - Minerals - metallic
Chemical Profile - Penicillin-derived compounds, calcium salts
Classification - Mineral-based compound
Use - Recognized in energetic homeopathic (nonmedical) practices
Description:
Penicillium Calcium, originating from metallic minerals, showcases a unique combination of penicillin-derived compounds and calcium salts. Its mineral-based structure is studied for its role in energetic homeopathic (nonmedical) practices. This compound is appreciated for its distinct chemical framework, documented in scientific and energetic homeopathic (nonmedical) literature, and valued for its specific mineral attributes. Recognized for its unique chemical structure. Check out related alternatives - Open Energetic Channel Link.
Chemical Profile - Penicillin-derived compounds, calcium salts
Classification - Mineral-based compound
Use - Recognized in energetic homeopathic (nonmedical) practices
Description:
Penicillium Calcium, originating from metallic minerals, showcases a unique combination of penicillin-derived compounds and calcium salts. Its mineral-based structure is studied for its role in energetic homeopathic (nonmedical) practices. This compound is appreciated for its distinct chemical framework, documented in scientific and energetic homeopathic (nonmedical) literature, and valued for its specific mineral attributes. Recognized for its unique chemical structure. Check out related alternatives - Open Energetic Channel Link.